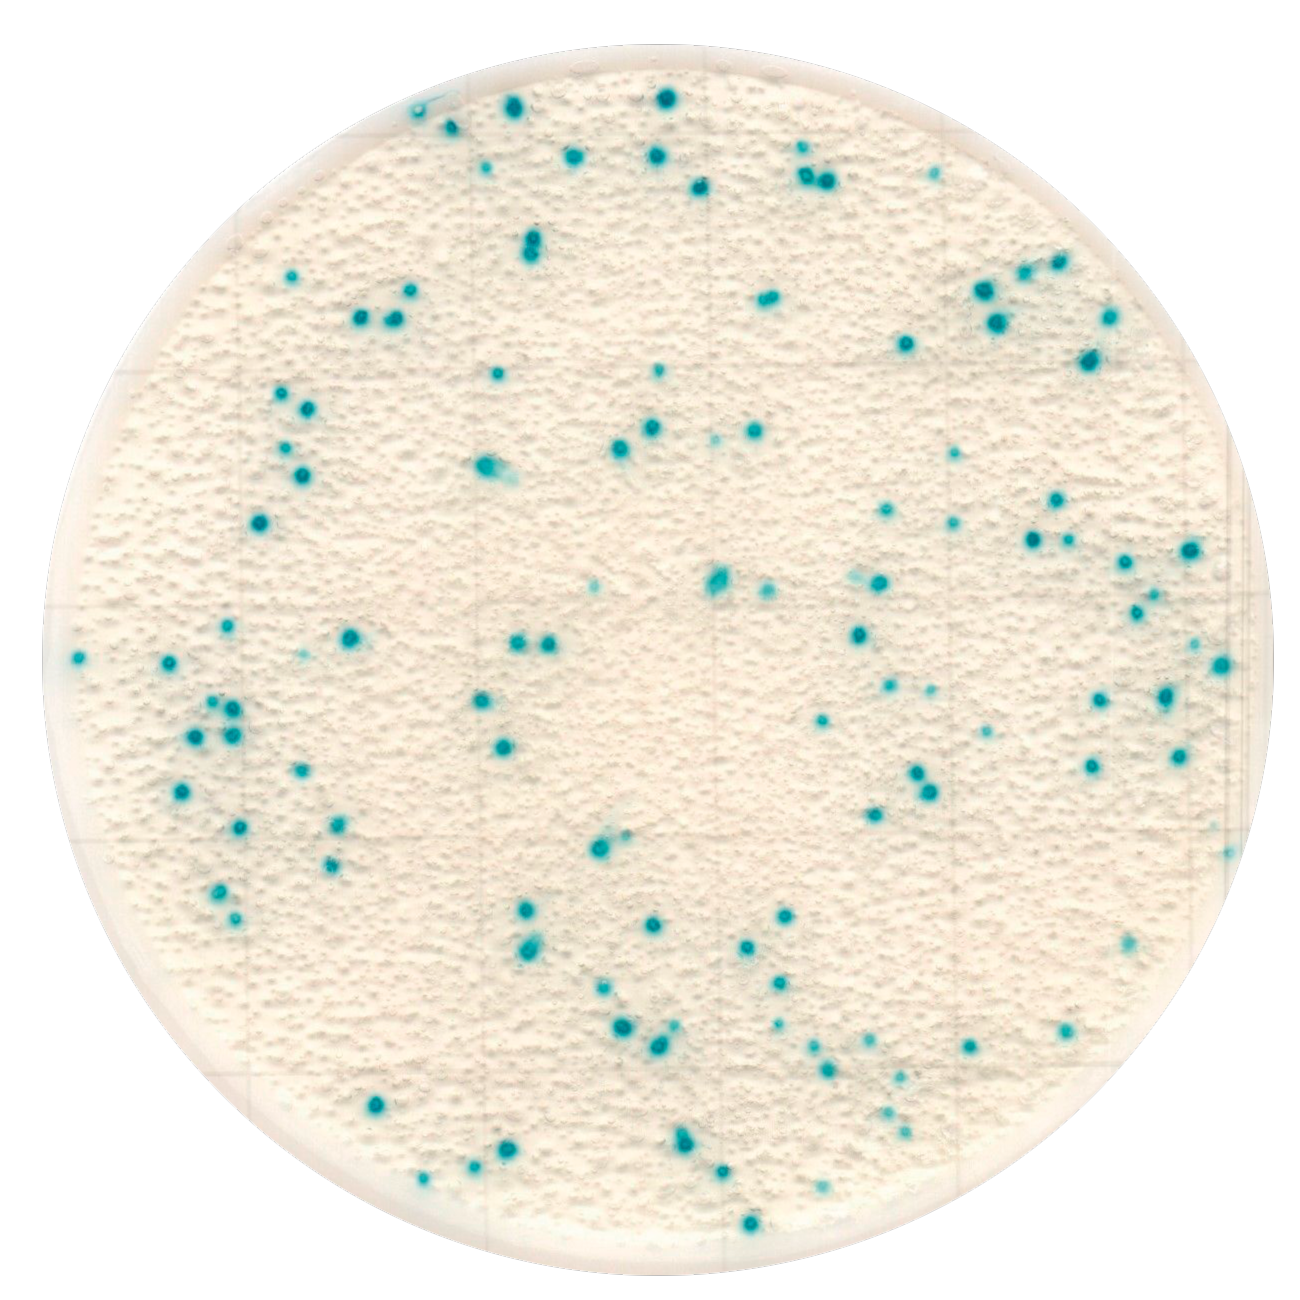
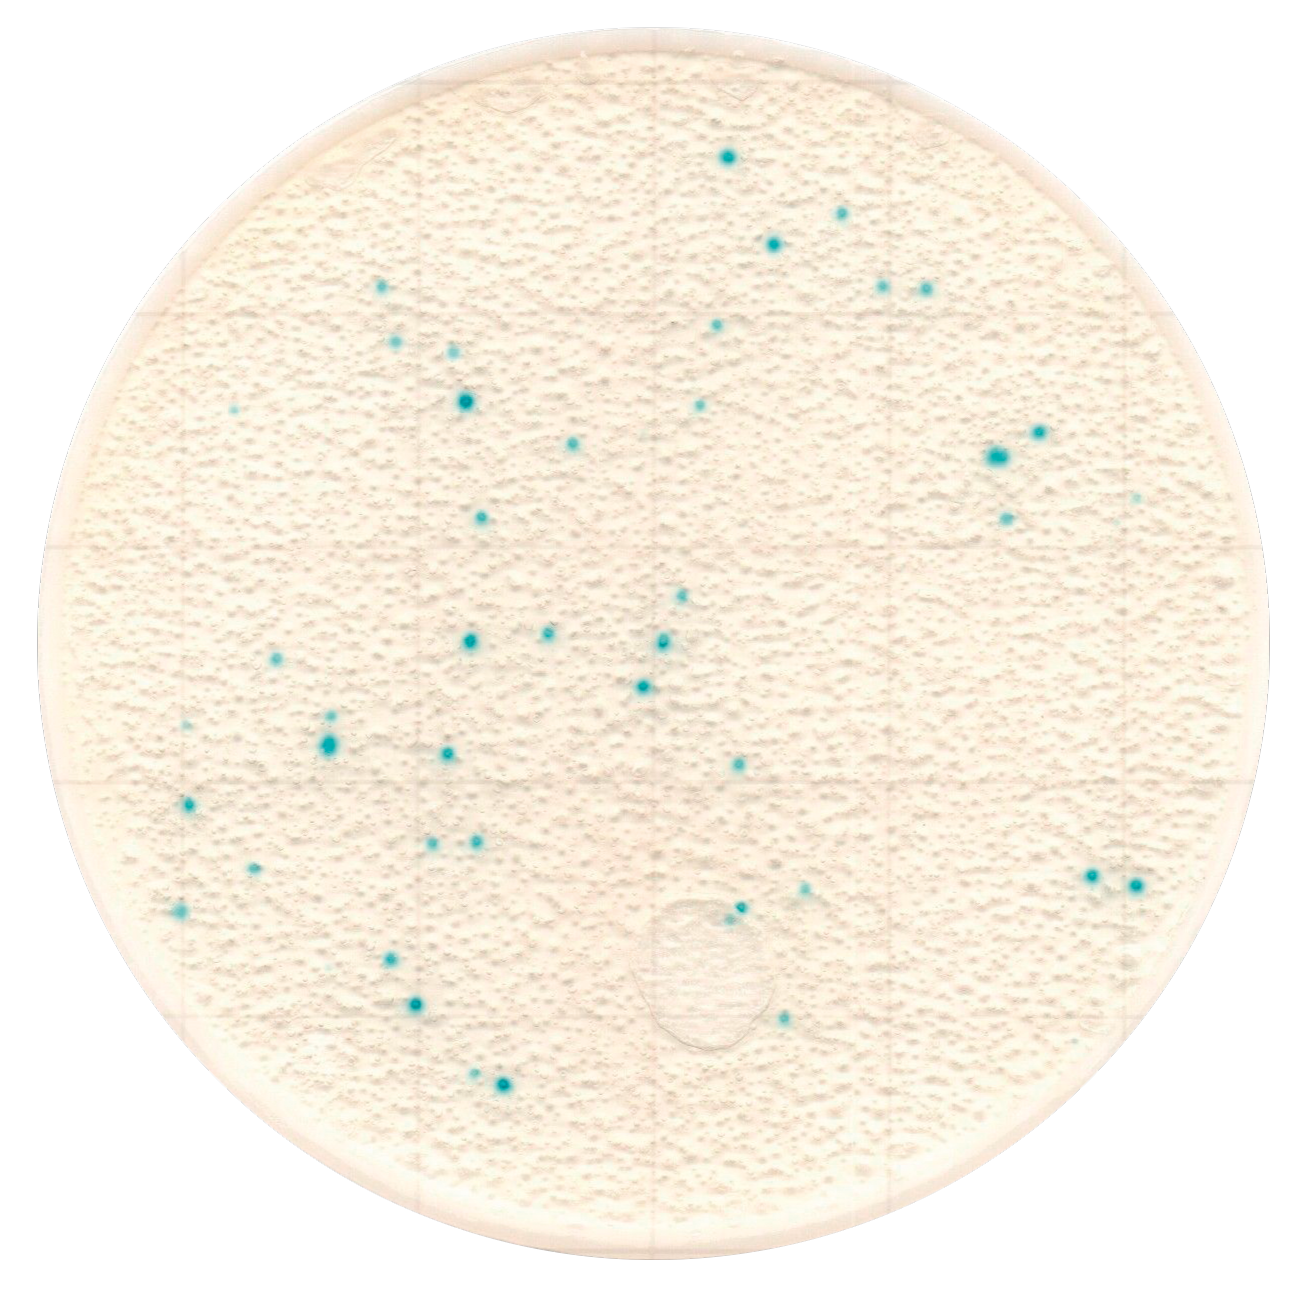
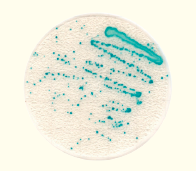

Easy Plate is a convenient, prepared media plate with no need for media preparation or sterilization. Easy Plate is an easy to use alternative to in-house media preparation using traditional plated media that saves time, labor and reduces waste. Using an Easy Plate – which is about 1/20 volume of the traditional petri dish – saves space and allows you to run more tests using current incubator space. Easy Plates come ready-to-use and immediately after opening the package you can place a sample suspension onto the media and start incubation.

Easy Plate LS is a custom media formulation for cultivation of Listeria species. A prepared plate that contains a chemical indicator that provides easily distinguishable blue-colored colonies, allowing you to easily identify and count Listeria species in 24±1 hours. Sold in packages of 100 tests in 4 separate bags containing 25 tests each.The shelf life of 18 months when stored unopened at 2-8℃.
Features
1. Easily distinguishable brightly colored colonies
Colonies turn blue, making them easy to visualize and count, even in the presence of food residue or other source of color.
| Easy Plate LS | ALOA agar |
 |
 |
Example: Listeria innocua (JCM 32814)
2. Excellent media performance
Faster Testing Enabled – Results equivalent to agar media in 24 hours.
Comparison of Performance : Easy Plate LS vs Plate Count Agar

Sample: Swabbed sample on artificially contaminated ceramic tile.
Swabbing solution: PBS
Strain: L. monocytogenes, Enterococcus faecalis
Coloring
Plate Count Interpretation
Count all blue colonies regardless of size or intensity.
The appropriate number of colonies is between 1 and 250.
Example
Strains
|
Listeria monocytogenes |
Listeria monocytogenes |
Listeria innocua |
 |
 |
|
|
Listeria welshimeri |
Listeria ivanovii |
Listeria garayi |
|
 |
 |
|
Listeria seeligeri |
||
 |
- Incubation conditions: 35℃, 24 hours (Diluent: phosphate buffered saline or buffered peptone water)
- These colorings are for example only.
How to Use
For Quantitative Test
 |
 |
 |
 |
 |
| A1) Lift the cover and place 1 mL sample suspension onto the center of the plate. | A2) Lower the cover onto the sheet and allow the sample to spread evenly. | A3) Allow the plate to settle for 3 min or more on a horizontal surface for solidification. | A4) lncubate the plate(s) at 35±1℃ or 37±1℃ for 24 hours. Up to 25 plates can be stacked. After incubation, count all blue colonies regardless of size or intensity. | [Optional] Colony lsolation: Lift cover and pick a single colony form the gel. |
For Qualitative Test
 |
 |
 |
 |
|
| B1)Sample the selecvely enriched culture solution. For selective enrichment,please use Half-Fraser broth or similar selective enrichment media. |
B2) Lift the cover and streak the selectively enriched culture onto the dry plate. | B3) Lift the cover and place 1 mL sterile water onto the center of the plate. | B4) Lower the cover onto the sheet and allow the sample to spread evenly.lncubate step is same as above step A4. |
Listeria |
* The sample preparation methods differ between environmental samples and food and beverage samples.
For the preparation methods applicable to each case, please refer to the instruction manual.
Product Specification
| Product Name | Easy Plate LS |
|---|---|
| Product Code | 61800 |
| Object microorganism | Listeria species |
| Incubation Times | 24 ± 1 hours |
| Incubation Temperature | 35 ± 1℃ of 37 ± 1℃ |
| Storage Condition (Unopened) | 2 - 8℃ |
| (After opening) | After opening the package, fold the open end of the package at least 2 times and tape it. Store in a refrigerator (2 to 8℃) and use within 3 months. |
| Shelf life | Shelf life 18 months after manufacturing date |
| Packaging | 100 tests (25 tests x 4 bags) |

